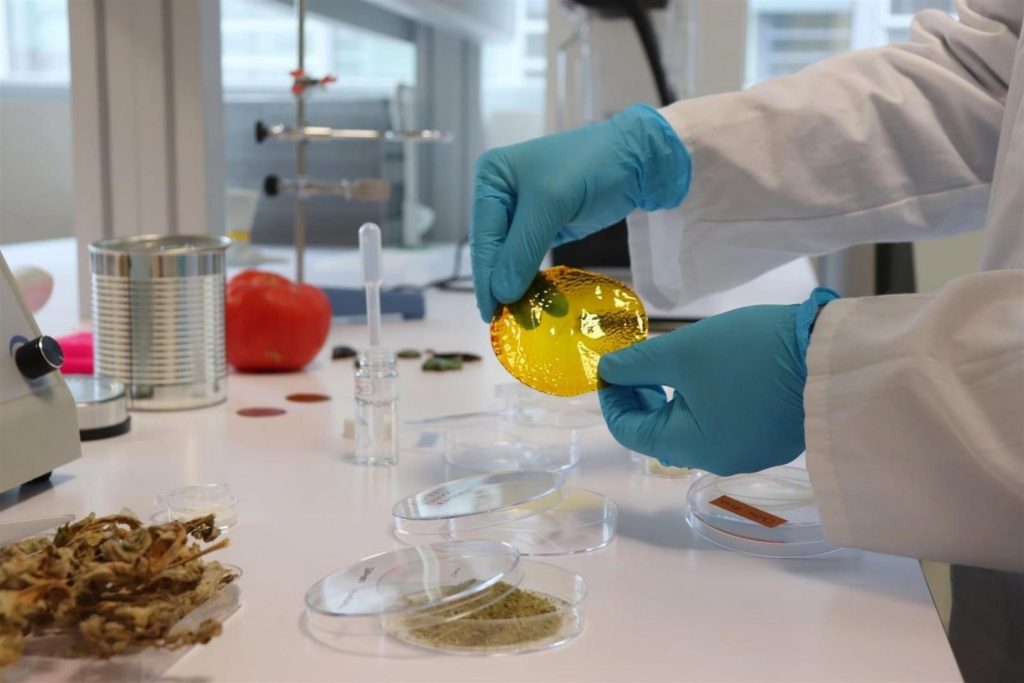
Bioplasticos

Unos bioplásticos producidos a partir de los restos y la piel del tomate, que se descomponen en solo un mes en el mar y con propiedades similares a los que protegen los envases comerciales, han sido creados por investigadores del Instituto de Hortofruticultura Subtropical y Mediterránea “La Mayora”.
El objetivo de estos científicos era crear una alternativa a los plásticos derivados del petróleo, que tienen unas propiedades excelentes para el envasado de alimentos, pero, cuando acaban en el mar, tardan 450 años en degradarse, se acumulan y causan problemas para la flora y fauna oceánica.

El investigador del IHSM, José Alejandro Heredia, trabaja con la celulosa para lograr el bioplástico ideal, capaz de ser modificado con sustancias bioactivas antibacterianas y antioxidantes, robustos, con muchas propiedades para el envasado de alimentos y que además potencien al máximo su facilidad para degradarse.
En busca del bioplástico ideal
De las hojas, los tallos y de la piel de los tomates que se desechan en la industria conservera tras hacer salsa de tomate o kétchup, se extrae la celulosa de forma purificada. A través de ésta, se crea una película o papel film robusto y transparente con múltiples aplicaciones, explica a Efe Heredia.
Estos bioplásticos pueden ser hidrófobos (que repelen el agua), fluorescentes, nacarados o de diversos colores y tonos según la exposición de la luz. Además, pueden utilizarse de una manera más lúdica para crear complementos como botones o adornos decorativos que imitan los materiales con los que se realizan habitualmente.
El “empaquetado inteligente” es otra de las revoluciones que proponen estos bioplásticos: una vez que protege un alimento, si el plástico deja de ser de su color inicial, significa que ha absorbido agua y está perdiendo su estructura, por lo que está empezando a perder propiedades antioxidantes y dejando de ser útil.
Plàsticos sostenibles e inteligentes
Actúa como una especie de “sensor” para darnos una pista o mostrarnos indicios de que un material que envuelve un alimento está empezando a deteriorarse, lo que en un plazo medio puede llegar a afectar al propio alimento que envuelve, según detalla el investigador.
Otra de las principales aplicaciones que pueden tener estos plásticos generados a través de los restos de tomate es recubrir el interior de una lata. Para la creación de éstos se utiliza un protocolo “muy sostenible” al que el científico denomina “química verde”.
Heredia asegura que, una vez llevado a cabo el proceso de producción de este bioplástico, se ha comprobado que es “tan bueno” como los comerciales actuales derivados del petróleo, ya que consiguen que el metal “resista muy bien la corrosión y no migran hacia el alimento”.
Sin embargo, lamenta el investigador, su aplicación comercial está lejos de llegar, ya que la industria de los plásticos necesita poder utilizar la misma maquinaria para que sea económicamente viable este cambio, que supondría una revolución para el medio ambiente y la sostenibilidad alimentaria.



Sin Comentarios